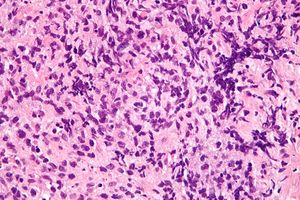

لمفومة الخلية البائية المنصفية الأولية
| لمفومة الخلية البائية المنصفة الأولية Primary mediastinal large B-cell lymphoma | |
|---|---|
| |
| صورة مجهرية للمفومة الخلية البائية المنصفة الأولية. | |
| التبويب والمصادر الخارجية | |
| التخصص | علم أمراض الدم وعلم الأورام |
| ICD-O | 9679/3 |
| eMedicine | article/203681 |
| Patient UK | فشل عرض الخاصية P1461: لم يتم العثور على الخاصية P1461. لمفومة الخلية البائية المنصفية الأولية |
لمفومة الخلية البائية المنصفية الأولية، اختصاراً PMBL، هي إحدى أنواع اللمفوما والتي تطهر في المنصف وغالباً ما تصيب البالغين الشباب.[1][2]
وهي نوع فرعي لمفوما الخلية البائية الضخمة المنتشرة[3]؛ ومع ذلك فهي غالباً ما يكون التنبؤ بمسار المرض أفضل بكثير.
انظر أيضاً
المصادر
- ^ Johnson, PW.; Davies, AJ. (2008). "Primary mediastinal B-cell lymphoma". Hematology Am Soc Hematol Educ Program. 2008: 349–58. doi:10.1182/asheducation-2008.1.349. PMID 19074109.
{{cite journal}}: Cite has empty unknown parameter:|month=(help) - ^ Coso, D.; Rey, J.; Bouabdallah, R. (Feb 2010). "[Primary mediastinal B-cell lymphoma]". Rev Pneumol Clin. 66 (1): 32–5. doi:10.1016/j.pneumo.2009.12.007. PMID 20207294.
- ^ "Types of Non-Hodgkin Lymphoma". www.cancer.org. Retrieved 2017-09-28.
وصلات خارجية
This article contains content from Wikimedia licensed under CC BY-SA 4.0. Please comply with the license terms.